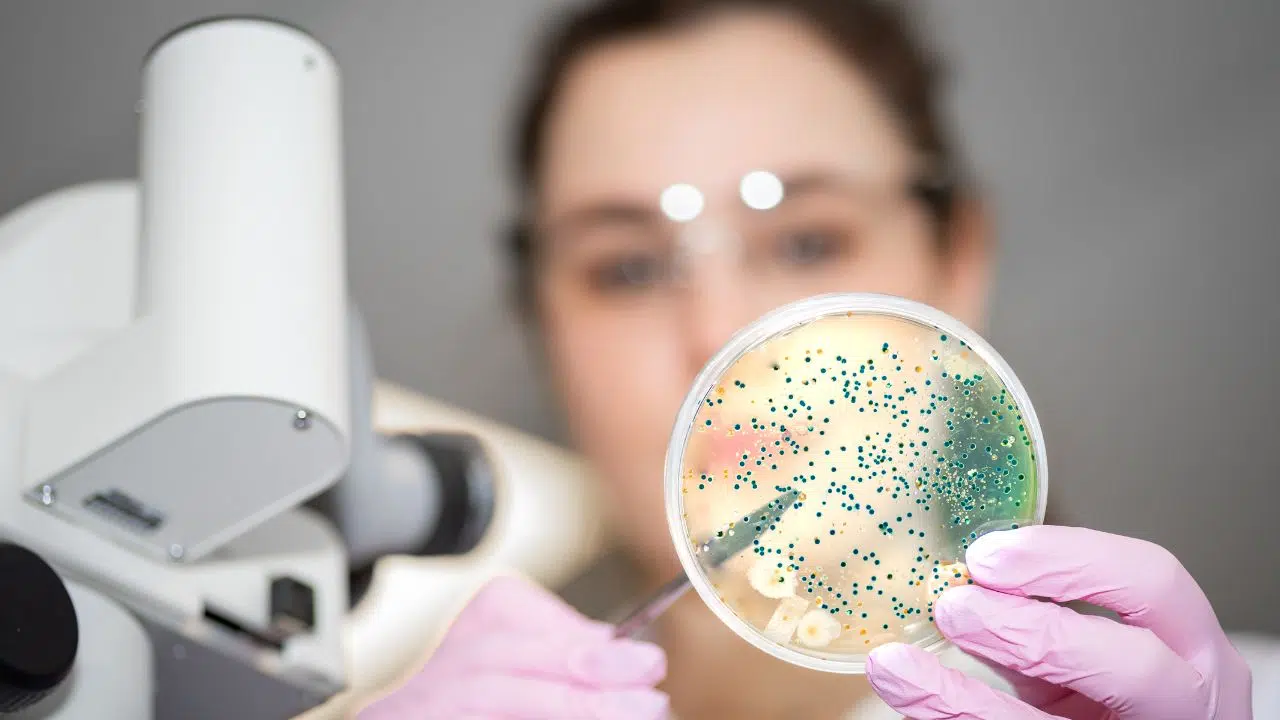
Nouvel outil d'évaluation des risques biologiques par l'Institut National de Recherche et de Sécurité (INRS)

Les risques biologiques en milieu professionnel constituent une préoccupation majeure pour les entreprises et les organismes de santé publique. Dans un contexte où les agents pathogènes tels que virus, bactéries, parasites et champignons peuvent compromettre la santé des travailleurs, des outils et des stratégies de prévention adaptés sont essentiels. L’Institut National de Recherche et de Sécurité (INRS) a développé un nouvel outil.
Comprendre les risques biologiques
Définition et impact
Les agents biologiques comprennent divers organismes ou substances produits par ces organismes qui peuvent présenter un danger pour la santé humaine. En milieu de travail, ces risques sont particulièrement élevés dans les secteurs comme les soins de santé, l’agroalimentaire, la gestion des déchets et le recyclage. L’exposition à ces risques peut entraîner des infections, des intoxications ou des réactions allergiques, affectant non seulement la santé des employés mais aussi leur productivité.
Secteurs concernés
Chaque secteur d’activité présente des défis uniques en matière de risques biologiques. Par exemple, dans le secteur de la santé, le personnel est régulièrement en contact avec des agents infectieux. Dans l’agroalimentaire, la contamination microbiologique des aliments peut survenir à différents stades de la production.
L’outil d’évaluation des risques biologiques de l’INRS
Présentation de l’outil
L’INRS a développé un outil d’évaluation des risques biologiques qui guide les entreprises dans l’identification des dangers et la mise en œuvre de mesures de prévention efficaces. Cet outil, qui s’appuie sur une approche de questions-réponses, est conçu pour être utilisé par des professionnels de tous secteurs, y compris ceux moins familiers avec les spécificités des risques biologiques.
Fonctionnement de l’outil
L’outil est structuré en trois étapes principales:
- Évaluation des risques: Identification des réservoirs d’agents biologiques et des expositions potentielles.
- Mesures de prévention: Proposition de mesures adaptées au contexte spécifique de l’entreprise.
- Plan d’action: Création d’un plan d’action personnalisé, intégrable au Document Unique d’Évaluation des Risques Professionnels (DUERP).
Avantages de l’outil
L’utilisation de cet outil permet aux entreprises de structurer leur démarche de prévention et d’assurer une protection efficace contre les risques biologiques. Il offre également un support pour la formation du personnel, élément clé dans la gestion des risques sanitaires.
Formation et information: Clés de la prévention
Modules de formation
L’INRS propose également des modules de formation en ligne, notamment un dédié aux risques biologiques, accessible aux Services de Prévention et de Santé au Travail (SPST). Ce module couvre:
- La définition et l’identification des agents biologiques.
- Les enjeux réglementaires et professionnels.
- La méthodologie d’évaluation des risques.
- Les stratégies de prévention à mettre en œuvre.
Impact de la formation
Ces formations jouent un rôle crucial en équipant les professionnels avec les compétences nécessaires pour évaluer et réduire les risques dans leurs environnements de travail. Elles contribuent à la création d’une culture de la sécurité et de la prévention au sein des organisations.
Face aux défis posés par les risques biologiques en milieu professionnel, l’approche proactive de l’INRS à travers ses outils d’évaluation et ses programmes de formation représente un atout majeur pour la sécurité et la santé au travail. En mettant l’accent sur l’évaluation rigoureuse des risques et sur l’éducation continue des travailleurs, ces initiatives sont essentielles pour prévenir les incidents et promouvoir un environnement de travail sûr.